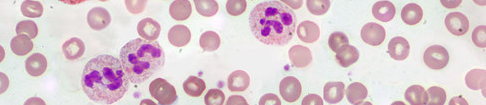
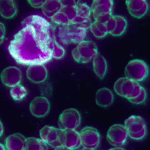
neutrophil
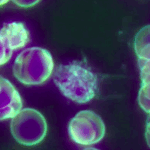
Pseudopod Dance
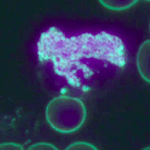
The Basophil’s Secret Signals

Welcome to Life Under the Lens — Dover’s unique wellness service, where you can witness your own blood come to life under the microscope.
This is a rare opportunity to see what is usually hidden: your blood cells moving, interacting, and telling their story in real time. Many people find it fascinating, sometimes even inspiring, to watch this living picture of their inner world.
It is important to note that this is not a medical test or diagnosis. Instead, it is an educational and empowering experience designed to increase your awareness of your body. By observing your blood in action, you may gain new insights that help you reflect on lifestyle, hydration, stress, or nutrition, and make more informed choices for your well-being.
Brightfield Microscopy
In conventional brightfield microscopy, stains or dyes are often applied to a sample. These chemicals provide contrast and make structures easier to see, but they come with a significant drawback: the process kills any living cells. What you see is no longer an active, dynamic system, but a fixed snapshot — useful for specific purposes, yet detached from the natural vitality of the sample.
Darkfield Microscopy
By contrast, darkfield microscopy allows us to view your blood cells alive and moving without the need for staining. Instead of passing light directly through the sample, the darkfield technique uses angled light so that only scattered light enters the lens. This creates a glowing, high-contrast view of living cells, plasma, and other structures — in real time.
This is why darkfield is especially valuable in our sessions: it lets you see your blood’s story unfolding as it truly is, in motion.
The Hidden World Within
Every drop of blood is alive with activity. Under darkfield microscopy, red and white cells reveal their hidden choreography — oxygen carriers flowing smoothly, and immune defenders constantly at work. Here are three windows into that unseen universe.
Why Choose Us?
- Based in Dover — no need to travel far.
- A wellness-first service — awareness, not diagnosis.
- Safe, simple, and non-invasive (just a tiny finger prick).
- You’ll always see your own blood on a computer monitor with clear, plain-English guidance.
- Empowering — most clients leave motivated to hydrate, rest, and eat better.
Services & Pricing
Clinic Sessions
Visit us for a private appointment in Dover.
- First Session (60 mins, £75) — discovery & darkfield introduction.
- Follow-Ups (30 mins, £45) — focused reviews and progress tracking.
- Packages available for 3 or 6 sessions
Learn more about Clinic Sessions
Gym / Wellness Centre Visits
Bringing Life Under the Lens to your workout space.
- Educational days hosted in local Gyms / Wellness Centres
- See your blood before and after exercise for a powerful comparison.
- Free for members — quick, safe, and motivating.
Learn more about Gym / Wellness Centre Visits
Home Visits
Enjoy the same experience in the comfort of your own home.
- A portable microscope setup brought to you.
- Ideal for those who prefer privacy or convenience.
- Family add-on option available.
Whichever option you choose, you will gain new perspectives within your body — because awareness is the first step to change.
Frequently Asked Questions
1. What is live blood observation?
Live blood observation uses a microscope to look at a tiny drop of your blood while it’s still fresh and moving. It’s not a medical test or diagnosis, but a fascinating way to learn how lifestyle factors may influence your wellbeing.
2. What’s the difference between darkfield and lightfield microscopy?
- Lightfield (brightfield): standard microscope view with a bright background, good for basic structures.
- Darkfield: cells glow brightly against a dark background, showing fine detail and movement.
3. Why do you use darkfield microscopy?
Because it provides a vivid, engaging view of your living blood. Clients can clearly see red blood cell shape, clumping, and white blood cell activity — details that lightfield often misses.
4. Why don’t you use lightfield if that’s the scientific standard?
Lightfield is excellent for laboratory slides and prepared samples, but it’s less striking for live blood. Darkfield isn’t about replacing science — it’s about giving clients the clearest, most motivating view of their living cells.
5. Does this replace medical blood tests?
No. Medical tests measure chemical levels in a lab (e.g. iron, cholesterol). Live blood observation is an educational experience, not a medical diagnosis.
💧 Hydration & Water Quality
Hydration
Hydration is the most critical factor we see under the microscope. When blood is well hydrated, the cells look lively and move freely. When the body is short of water, blood can become sticky and clotted, making it harder to see clearly and more challenging for your body to function at its best.
For the clearest results, we recommend drinking at least 2 litres of water daily for at least three days before your session.
Water Quality
Many people also ask about water quality. Over the years, we’ve observed that the type of water you drink can make a difference. Some people choose filtered or energised water and feel it helps them stay refreshed. The most important thing is finding water that you enjoy drinking, and making hydration a consistent part of your daily routine.
Quantity matters — and so does quality.
Contact Page
Get in touch to book your session or ask any questions.
📞 Phone: [Your number]
📧 Email: [Your email]
📍 Location: Dover

Disclaimer
Disclaimer